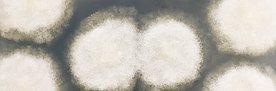

Klein, aber oho: Wir schauen ganz genau hin

Autoren:
Eidg. Forschungsanstalt WSL
Reihe:
WSL-Magazin Diagonal
2024/2
Erscheinungsjahr:
2024
Umfang:
40 Seiten
Download
Zitat:
Eidg. Forschungsanstalt WSL (2024). Klein, aber oho: Wir schauen ganz genau hin. WSL-Magazin Diagonal, 2024/2: 40 S.
Verfügbare Sprachen:
Deutsch,
Englisch,
Französisch